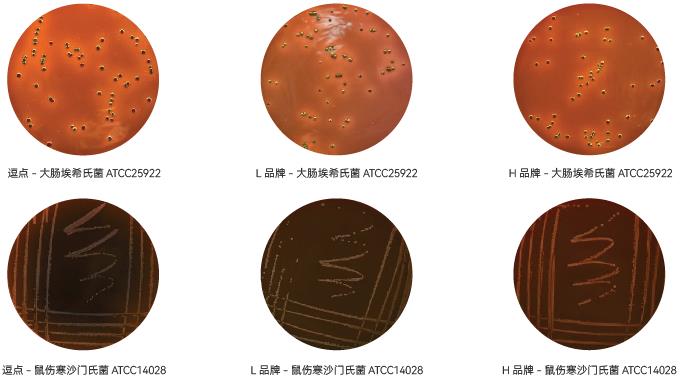

一、概述
1.1适用范围
本标准规定了食品中大肠埃希菌(Escherichia coli)计数的方法。
本标准适用于食品中大肠埃希菌的计数,其中大肠埃希菌平板计数法(第二法)不适用于贝类产品。
1.2检测原理
大肠埃希菌广泛存在于人和温血动物的肠道中,是革兰阴性杆菌,无芽胞,能够在44.5℃发酵乳糖产酸产气,IMViC(靛基质、甲基红、VP试验、柠檬酸盐)生化试验为++--或-+--的革兰阴性杆菌。以此作为粪便污染指标来评价食品的卫生状况,推断食品中肠道致病菌污染的可能性。

二、设备与耗材
2.1 设备
除微生物实验室常规灭菌及培养设备外,其他设备如下:
2.1.1 恒温培养箱 36℃±1℃。
2.1.2 冰箱2~5℃。
2.1.3 恒温水浴箱44.5℃±0.2℃。
2.1.4 天平 感量为0.1g。
2.1.5 拍打式均质器或刀头式均质器。
2.1.6 涡旋混匀器。
2.1.7 菌落计数器。
2.1.8 pH计或pH比色管。
2.1.9 紫外灯波长360~366 nm,功率≤6W。
2.2耗材
2.2.1 无菌吸管 1ml(具0.01mL刻度)、10mL(具0.1mL刻度)
或微量移液器及吸头。
2.2.2 接种针。
2.2.3 接种环(10μL)。
2.2.4 精密pH试纸。
2.2.5 无菌锥形瓶 容量500mL。
2.2.6 无菌培养皿 直径90mm。
三、培养基与试剂
3.1 培养基
3.1.1 月桂基硫酸盐胰蛋白胨(LST)肉汤。
3.1.2 EC肉汤(E.coli broth)。
3.1.3 蛋白胨水。
3.1.4 缓冲葡萄糖蛋白胨水[甲基红(MR)和V-P试验用]。
3.1.5 西蒙柠檬酸盐培养基。
3.1.6 磷酸盐缓冲液。
3.1.7 伊红美蓝(EMB)琼脂。
3.1.8 营养琼脂斜面。
3.1.9 结晶紫中性红胆盐琼脂(VRBA)。
3.1.10结晶紫中性红胆盐-4-甲基伞形酮-β-D-葡萄糖苷琼脂(VRBA-MUG)。
3.2试剂
3.2.1 革兰染色液。
3.2.2 Kovacs靛基质试剂。
3.2.3无菌1mol/LNaOH。
3.2.4无菌1mol/LHCl。
四、检验过程
4.1 大肠埃希菌MPN法(第一法)
4.1.1 检验程序
大肠埃希菌MPN计数的检验程序见流程图13-1

4.1.2操作步骤
4.1.2.1样品的稀释 固体和半固体样品:用天平无菌称取25g样品;如使用刀头式均质器,可将样品加入盛有225mL磷酸盐缓冲液的无菌均质杯内,8000~10000r/min均质1~2分钟,制成1:10的样品匀液;如使用拍打式均质器,可将样品加入盛有225mL磷酸盐缓冲液的无菌均质袋中,拍打1~2分钟,制成1:10的样品匀液。
液体样品:用无菌吸管吸取25mL样品;如使用锥形瓶,可将样品加入盛有225mL磷酸盐缓冲液的无菌锥形瓶(瓶内预置适当数量的无菌玻璃珠)中,充分混匀,制成1:10的样品匀液;如使用均质袋,可将样品放入盛有225mL磷酸盐缓冲液的无菌均质袋中,拍打1~2分钟,制成1:10的样品匀液。
如为冷冻产品,应在45℃以下(如水浴中)不超过15分钟解冻,或2~5℃冰箱中不超过18小时解冻。
样品匀液的pH值应在6.5~7.5之间,必要时分别用1mol/LNaOH或1mol/LHCl调节。
用1mL无菌吸管或微量移液器吸取1:10样品匀液1mL,沿管壁缓缓注入9mL磷酸盐缓冲液的无菌试管中(注意吸管或吸头尖端不要触及稀释液面),振摇试管或换用1支1mL无菌吸管或吸头反复吹打,使其混合均匀,制成1:100的样品匀液。
根据对样品污染状况的估计,按上述操作,依次制成10倍递增系列稀释样品匀液。每递增稀释1次,换用1支1mL无菌吸管或吸头。从制备样品匀液至样品接种完毕,全过程不得超过15分钟。
4.1.2.2初发酵试验 根据样品污染状况或产品限量标准要求,选择3个适宜的连续稀释度的样品匀液(液体样品可以选择原液),每个稀释度接种3管月桂基硫酸盐胰蛋白胨(LST)肉汤,每管接种1mL(如接种量超过1mL,则用双料LST肉汤)(注意:如果样品匀液静置超过3分钟应重新混匀后再接种),36℃±1℃培养(24±2)小时,观察小倒管内是否有气泡产生,(24±2)小时产气者进行复发酵试验,如未产气则继续培养至(48±2)小时。产气者进行复发酵试验。如所有LST肉汤管均未产气,即可报告大肠埃希菌MPN结果。

4.1.2.3复发酵试验 用接种环从产气的LST肉汤管中分别取培养物1环(约10μL),移种于已提前预温至45℃的EC肉汤管中,放入带盖的44.5℃±0.2℃水浴箱内。注意水浴的水面应高于肉汤培养基液面,培养(24±2)小时,检查小倒管内是否有气泡产生,如未有产气则继续
培养至(48±2)小时。记录在24小时和48小时内产气的EC肉汤管数。如所有EC肉汤管均未产气,即可报告大肠埃希菌MPN结果;如有产气者,则进行EMB平板分离培养。

4.1.2.4伊红美蓝平板分离培养 轻轻振摇各产气管,用接种环取培养物分别划线接种于EMB平板,36℃±1℃培养18~24小时。观察平板上有无具黑色中心有光泽或无光泽的典型菌落。典型菌落为具有黑色中心,有或无金属光泽的菌落。非典型的可疑菌落为粉红色、无黑心的菌落。
4.1.2.5营养琼脂斜面或平板培养 从每个平板上挑5个典型菌落,如无典型菌落则挑取可疑菌落。用接种针接触菌落中心部位,移种到营养琼脂斜面或平板上,36℃±1℃培养18~24小时。
4.1.2.6鉴定 取营养琼脂培养基上的纯培养物进行革兰染色、靛基质试验、MR-VP试验和柠檬酸盐利用试验。生化鉴定可选择生化鉴定管、生化鉴定试剂条或全自动微生物生化鉴定系统进行鉴定。大肠埃希菌与非大肠埃希菌的生化鉴别。

表13-1:

注:菌悬液浓度不宜过大,否则可能产生假阳性结果。
4.1.2.6.1革兰染色 用10μl接种环挑取0.85%的无菌生理盐水1环在载玻片中央,挑取可疑单菌落涂布成一均匀的薄层,手持载玻片一端,标本向上,待菌液干燥后,在酒精灯上加热固定,温度不宜过烫,放置待冷后进行染色。结晶紫初染1分钟,碘液1分钟,乙醇脱色30秒,复染1分钟。
注意:每步染色后,需斜置载玻片,用小水流冲洗,直至洗下的水呈无色为止,注意冲洗时不要直接冲洗涂层表面。待标本干后置显微镜油镜下观察。
染色结果:大肠埃希菌为革兰阴性杆菌,长度为1~3μm,无芽胞。

4.1.2.6.2靛基质试验挑取适量营养琼脂培养物,接种于蛋白胨水试管中,于36℃±1℃培养(24±2)小时。取出试管后滴加Kovacs靛基质试剂,阳性结果为接触面呈红色,阴性结果为接触面呈黄色。典型大肠埃希菌为阳性,非典型为阴性。
4.1.2.6.3 甲基红试验 挑取适量营养琼脂培养物,接种于缓冲葡萄糖蛋白胨水试管中,于36℃±1℃培养2~5天。取出试管后滴加甲基红试剂,阳性结果为红色,阴性结果为黄色。大肠埃希菌为阳性反应。
4.1.2.6.4 VP试验 挑取适量营养琼脂培养物,接种于缓冲葡萄糖蛋白胨水试管中,于36℃±1℃培养2~4天。取出试管后滴加VP1试剂1滴和VP2试剂1滴,观察结果,阳性反应立刻或于数分钟内出现红色,阴性结果为黄色。如为阴性,应放在36℃±1℃继续培养4小时再进行观察。大肠埃希菌为阴性。
4.1.2.6.5 柠檬酸盐利用试验 挑取适量营养琼脂培养物,接种于西蒙柠檬酸盐培养基中,于36℃±1℃培养(24±2)小时。观察结果,阳性结果为培养基变蓝色,阴性结果为绿色不变色。大肠埃希菌为阴性。
4.1.3大肠埃希菌MPN计数 大肠埃希菌为革兰阴性无芽胞杆菌,发酵乳糖、产酸、产气,IMViC生化试验为++--或-+--。只要有1个菌落鉴定为大肠埃希菌,其所代表的LST肉汤管即为大肠埃希菌阳性。依据LST肉汤阳性管数查MPN表。
4.1.4结果报告 报告每g(ml)样品中大肠埃希菌的MPN值,以MPN/g(ml)表示。
4.2大肠埃希菌平板计数法(第二法)
4.2.1 检验程序 大肠埃希菌平板计数法的检验程序。

4.2.2操作步骤
4.2.2.1 样品的稀释 按4.1.2.1进行。
4.2.2.2平板计数
4.2.2.2.1 选取2~3个适宜的连续稀释度的样品匀液,每个稀释度接种2个无菌平皿,每皿1ml。同时取1ml稀释液加入无菌平皿做空白对照。
4.2.2.2.2 将10~15ml冷至45℃±0.5℃的结晶紫中性红胆盐琼脂(VRBA)倾注于每个平皿中。小心旋转平皿,将培养基与样品匀液充分混匀。待琼脂凝固后,再加3~4ml VRBA-MUG覆盖平板表层。凝固后翻转平板,36℃±1℃培养18~24小时。
4.2.2.3 平板菌落数的选择 选择菌落数在10~100CFU之间的平板,暗室中360~366nm波长紫外灯照射下,计数平板上发浅蓝色荧光的菌落。
检验时用已知MUG阳性菌株(如大肠埃希菌ATCC 25922)和产气肠杆菌(如ATCC 13048)做阳性和阴性对照。

4.2.3大肠埃希菌平板计数的报告 两个平板上发荧光菌落数的平均数乘以稀释倍数,报告每g(ml)样品中大肠埃希菌数,以CFU/g(ml)表示。若所有稀释度(包括液体样品原液)平板均无菌落生长,则以小于1乘以最低稀释倍数报告。
五、检验注意事项
5.1 实验过程中,每批样品稀释液都要做空白对照。如果空白对照肉汤管中或平板上出现菌落时,应废弃本次实验结果,并对稀释液、吸管、培养皿、培养基、实验环境等进行污染来源分析。
5.2初发酵实验时用磷酸盐缓冲液分别加入LST肉汤单料和双料中作为空白对照。
5.3检验时定期使用大肠埃希菌ATCC 25922菌种或等效菌株和产气肠杆菌ATCC 13048或等效菌株,在BSL-2实验室或阳性对照实验室内,用适当的食品样品进行阳性对照和阴性对照实验验证,染菌剂量应控制在10~100CFU/25g样品,并进行记录。
5.4每批所使用的培养基和生化试剂进行质量性能测试,质控方法见GB 4789.28—2013,并记录测试结果。
5.5检验中所使用的试验耗材,如培养基、稀释液、培养皿、吸管等必须是无菌的,重复使用的耗材应彻底洗涤干净,不得残留抑菌物质。
5.6对含有较大颗粒残渣的样品(如肉类)进行检测时,建议使用带滤网均质袋,以方便均质后用吸管吸取匀液。
5.7 应用本检验方法对食品样品进行大肠埃希菌计数检验时,从制备一个样品匀液至样品接种完毕,全过程不得超过15分钟。
5.8在进行样品的10倍稀释过程中,吸管应插入检样稀释液液面2.5cm以下,取液应先高于1ml,而后将吸管尖端贴于试管内壁调整至1ml,这样操作不会有过多的液体黏附于管外。将1ml液体加入另一9ml试管内时应沿管壁加入,不要触及管内稀释液,以防吸管外部黏附的液体混入其中影响检测结果。
5.9本方法移液时可使用能连接吸管的电动移液器,在使用过程中,一旦液体进入电动移液器滤膜中,应立即对滤膜进行更换,以防止交叉污染。鉴于微量移液器移液头较短,为控制污染,在本方法移液过程中不应使用。
5.10结晶紫中性红胆盐琼脂(VRBA)和VRBA-MUG琼脂使用前临时制备,煮沸灭菌后保存时间不得超过3小时。
5.11 在使用MUG测定法之前,检查所使用的培养皿是否自带荧光。培养皿直径应不低于90mm,倾注琼脂厚度应不低于3mm。
5.12倾注培养基后,可将培养皿底在平面上先向一个方向旋转3~5次,然后再向反方向旋转3~5次,以充分混匀。旋转过程中不应力度过大,避免琼脂飞溅到培养皿上方。混匀过程也可使用自动培养皿旋转仪进行。
5.13 当样品中含有吸水性物质(如淀粉、面粉等)时,应以最快速度进行琼脂倾碟,以防凝块产生。
5.14在培养箱中,为防止中间培养皿过热,平板的叠放高度不得超过6个培养皿。
5.15 当使用功率较大的紫外灯时,如15W紫外灯,应带上防紫外线的眼镜和手套。
六、疑难解析
6.1 大肠菌群、粪大肠菌群和大肠埃希菌的区别是什么?
大肠菌群,是指在一定培养条件下能发酵乳糖、产酸产气的需氧和兼性厌氧革兰阴性无芽胞杆菌,培养温度为36℃±1℃,其可能来自人类和温血动物的肠道及自然环境,包括埃希菌属、柠檬酸菌属、克雷伯菌属和肠杆菌属等。
粪大肠菌群,又称为耐热大肠菌群,是一群在44.5℃培养24~48小时能发酵乳糖、产酸产气的需氧和兼性厌氧革兰阴性无芽胞杆菌,主要由大肠埃希菌组成,还包括与粪便污染无直接相关性的其他菌株,例如肺炎克雷伯菌。
大肠埃希菌,属于肠杆菌科埃希菌属,其广泛存在于人和温血动物的肠道中,是革兰阴性杆菌,无芽胞,能够在44.5℃发酵乳糖产酸产气,IMViC生化试验结果为“++--”或“-+--”。因此,相对于大肠菌群和粪大肠菌群,大肠埃希菌与粪便污染的相关性最好,故以此作为粪便污染指标来评价食品的卫生状况,推断食品中肠道致病菌污染的可能性。
6.2大肠埃希菌计数的两种方法检验原理及适用范围是什么?
我国食品中大肠埃希菌的检验依据是《食品安全国家标准 食品微生物学检验 大肠埃希菌计数》(GB4789.38—2012),共有两个方法:
第一法大肠埃希菌MPN计数:主要利用大肠埃希菌可以在44.5℃±0.2℃发酵乳糖产酸产气的原理进行检测,样品经系列稀释并在44.5℃±0.2℃培养后,根据其未生长的最低稀释度与生长的最高稀释度,应用统计学概率论推算出待测样品中大肠埃希菌的最大可能数。此方法适用于污染菌量较少的食品。
第二法大肠埃希菌平板计数法:主要利用超过95%的大肠埃希菌可产生β-葡糖醛酸糖苷酶(GUD)活性的原理进行检测,可与VRBA-MUG平板中底物4-甲基伞形酮-β-D-葡萄糖苷(MUG)反应使4-甲基伞形酮(MU)游离;在360~366nm波长紫外灯照射下,MU显示蓝色荧光,通过计数产生荧光的菌落测定食品中大肠埃希菌的数量。与MPN计数法相比,检测结果更为精确,适用于污染比较严重的食品。
6.3大肠埃希菌平板法为什么不适用于贝类?
VRBA-MUG平板计数法的检测原理:超过95%的大肠埃希菌具有β-葡糖醛酸糖苷酶(GUD),可与平板中底物4-甲基伞形酮-β-D-葡萄糖苷(MUG)反应生成4-甲基伞形酮(MU),在360~366nm波长紫外灯照射下,MU显示蓝色荧光,通过计数产生荧光的菌落测定食品中大肠埃希菌的数量。而贝类如牡蛎含有内源性GUD,会与培养基底物进行反应产生荧光,干扰计数结果的准确性。
此外,肠杆菌科中GUD阳性的细菌除了大肠埃希菌之外,还有某些志贺菌、沙门菌和耶尔森菌,但考虑到这些菌都是致病菌,所以这种假阳性在公共卫生学上不认为是缺陷。
本方法有大约4%的假阴性,特别是倍受关注的O157:H7大肠埃希菌β-葡萄糖苷酸酶也为阴性,用本方法检测为阴性反应。
参考文献: <食品检验操作技术规范(微生物检验)>中国食品药品检定研究院附录A
月桂基硫酸盐胰蛋白胨肉汤(LST)1、产品用途:月桂基硫酸盐盐胰蛋白胨肉汤用于多管发酵法测定大肠菌群和粪大肠菌群。
2、检验原理:胰蛋白胨提供碳源和氮源满足细菌生长的需求;氯化钠可维持均衡的渗透压;乳糖是大肠菌群可发酵的糖类;磷酸二氢钾和磷酸氢二钾是缓冲剂;月桂基硫酸盐钠可抑制非大肠菌群细菌的生长。

表13-2:月桂基硫酸盐胰蛋白胨肉汤(LST)验证数据

3、典型特征图片:

4、验证结果小结:
4.1生长率:目标菌大肠埃希氏菌ATCC25922 、弗氏柠檬酸杆菌ATCC43864、逗点、陆桥、环凯的混浊度、产气均满足要求;
4.2选择性:粪肠球菌 ATCC29212,逗点、陆桥、环凯均满足不生长、不产气的要求;
4.3感观:逗点、L品牌、H品牌外观颜色无明显差异。
附录B伊红美蓝(EMB)琼脂培养基验证1、产品用途:用于分离革兰氏阴性肠道菌特别是大肠菌群和粪大肠菌群。
2、检验原理:蛋白胨提供碳源和氮源;乳糖是大肠菌群可发酵的糖类;磷酸氢二钾是缓冲剂;琼脂是培养基凝固剂;伊红和美蓝是抑菌剂和 pH 指示剂,可抑制革兰氏阳性菌,在酸性条件下产生沉淀,形成紫黑色菌落或具黑色中心的外围无色透明的菌落。

表13-3:红美蓝(EMB)琼脂培养基验证

3、典型特征图片:

4、验证结果小结:
4.1生长率:目标菌大肠埃希氏菌 ATCC25922,逗点、L品牌、H品牌均满足国标PR≥0.5;黑色菌落,具金属光泽的要求;且三家无明显差异。
4.2特异性:鼠伤寒沙门氏菌 ATCC14028,逗点、L品牌、H品牌均满足国标菌落呈无色、半透明;且三家无明显差异。
4.3选择性:金黄色葡萄球菌 ATCC6538, 逗点、L品牌、H品牌均满足国标G<5的要求;且三家无明显差异。
4.4感观:逗点、H品牌平板颜色无明显差异,L品牌平板颜色稍微深一点。
附录C
EC肉汤验证1、产品用途:用于多管发酵法测定粪大肠菌群和大肠杆菌的确证试验。
2、检验原理:胰蛋白胨提供碳氮源;3号胆盐抑制革兰氏阳性菌;乳糖是可发酵的糖类;磷酸氢二钾和磷酸二氢钾为缓冲剂;氯化钠可维持均衡的渗透压。

表13-4:EC肉汤验证

3、典型特征图片:

4、验证结果小结:
4.1生长率:目标菌大肠埃希氏菌ATCC25922,逗点、L品牌、H品牌均满足国标混浊度2,且气体充满管内1/3的要求,H品牌混浊度最明显;
4.2选择性:粪肠球菌ATCC29212,逗点、L品牌、H品牌均满足国标混浊度0(不生长)的要求;
4.3感观:逗点、L品牌、H品牌空白肉汤颜色无显著差异。
附录D结晶紫中性红胆盐MUG琼脂培养基(VRBA-MUG)验证1、产品用途:用于食品中大肠埃希氏菌的平板法计数。
2、检验原理:蛋白胨和酵母膏粉提供碳氮源和微量元素;乳糖是可发酵的糖类;氯化钠可维持均衡的渗透压;3号胆盐和结晶紫抑制革兰氏阳性菌,特别抑制革兰氏阳性杆菌和粪链球菌;中性红为pH指示剂;琼脂为凝固剂;大肠埃希菌含有的葡萄糖醛酸苷酶作用于4-甲基伞形酮-β-D葡萄糖醛酸苷(4-Methylumbellifery-β-D-Glucuronide简称MUG)的β糖醛酸苷键,使其水解,释放的4-甲基伞形酮在366nm紫外灯下产生蓝白色荧光。97%的大肠埃希菌、10%的沙门氏菌以及少量的志贺氏菌具有葡萄糖醛酸苷酶。

表13-5:结晶紫中性红胆盐MUG琼脂培养基(VRBA-MUG)验证

3、典型特征图片:


4、验证结果小结:
4.1生长率:目标菌大肠埃希氏菌ATCC25922,逗点、L品牌、H品牌均满足国标PR≥0.7,带有沉淀环的紫红色或红色菌落,有荧光的要求,逗点生长率最好,菌落比L品牌、H品牌偏小;
4.2选择性:弗氏柠檬酸杆菌ATCC43864,逗点、L品牌、H品牌均满足国标可带有沉淀环的红色菌落,无荧光的要求;
4.3选择性:粪肠球菌ATCC29212,逗点、L品牌、H品牌均满足国标G<5的要求;
4.4感观:逗点空白平板颜色较鲜红,L品牌、H品牌空白平板颜色无显著差异。